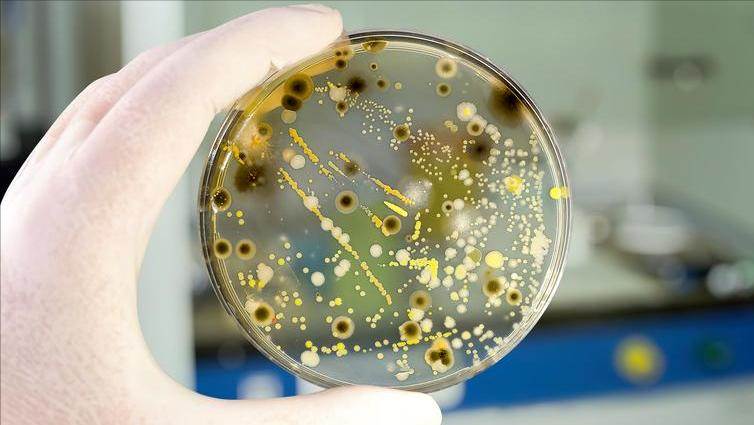

10歲男孩確診白血病,主任提醒:床頭這4樣東西,很多人忽略了

更令人擔憂的是,這些化學物質有的具備「內分泌干擾」作用,可能影響孩子的發育,甚至被懷疑與某些癌癥有關。

第四個,是很多人都會忽略的:未清洗的床頭靠枕、毛絨玩具。
這類物品是塵螨、霉菌、細菌的「溫床」。尤其是長時間暴露在潮濕或不通風的房間里,霉菌孢子容易滋生。孩子呼吸道黏膜脆弱,睡前抱著毛絨玩具、枕著靠墊入睡,等于把這些微生物吸進了肺里。
有研究指出,霉菌暴露與哮喘、呼吸道感染、甚至某些免疫系統異常有關。雖然不會直接導致白血病,但作為一個影響免疫系統負擔的因素,不能忽視。

講到這里,有人可能會覺得這太「挑剔」了,家里哪能做到百分百無污染?確實,完美的環境幾乎不存在,但問題在于——是否有意識去改善。
特別是家里有孩子或老人的,更需要注意這些看似不起眼的細節。
他們的身體沒那麼強壯,很多時候是靠我們來守護。
有位老人曾分享過一句話:「現在的孩子太干凈了,反而容易生病。」這話在某種程度上有它的道理,但也不能誤解為「臟一點沒關系」。
生活的「干凈」,不光是指洗手、洗澡,更是空氣的干凈、環境的干凈、用品的安全。這種干凈,不是表面上的,而是看不見的、卻最重要的。
小時候,很多人家里沒這麼多講究,也沒那麼多東西,那時候的生活雖然簡樸,但反倒少了現在這些化學制品的干擾。
如今生活條件好了,反而更容易被物質包圍,而忽略了最基本的健康底線。
有時候一件小事,改變的不只是環境,還有思維的方式。有人搬新家后,會一次性買下全套香薰、裝飾、夜燈,覺得「家要有味道」。但有沒有想過,那些「味道」的來源是什麼?是否真的適合家里的孩子或老人?

又很多年輕人喜歡用空氣清新劑噴噴灑灑,噴完就關窗,覺得這樣「香香的」。
可那些香味往往來自揮發性有機物,長期吸入,反而對身體是一種負擔。
并不是要大家一味恐慌、聽風就是雨。而是希望,能在這類事件發生前,多一個提醒,多一個判斷。
每一個家庭,都值得一個更安心的睡眠環境。每一個孩子,都不該在年紀輕輕時就承擔身體上的苦。每一個忽略過這些細節的父母,也都值得被理解——現在知道總比永遠不知道要好。
如果要說這篇文章能帶來什麼改變,那就是——今晚睡前,有人會重新看一眼自己的床頭柜。
也許那個香薰會被拿走,那個夜燈會被換掉,那只積了灰的毛絨玩具,會被洗一洗、曬一曬。
或許改變并不大,但只要開始了,就是好事。
聲明:本文為健康知識科普,結合權威資料和個人觀點撰寫,部分情節為方便表達和閱讀理解進行了適當虛構與潤色,內容僅供參考,不能替代醫生診斷。如感不適,請及時就醫。











